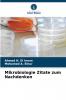
Mikrobiologie Zitate zum Nachdenken

German
Paperback
₹8039
₹10597
24.14% OFF
(All inclusive*)
Delivery Options
Please enter pincode to check delivery time.
*COD & Shipping Charges may apply on certain items.
Review final details at checkout.
Looking to place a bulk order? SUBMIT DETAILS
About The Book
Description
Author(s)
„Microbiology Quotable Quotes fasst die grundlegenden Informationen zur allgemeinen und systemischen Mikrobiologie zusammen ordnet sie und vereinfacht sie. Dieses Buch ist von großem Interesse da es so konzipiert ist dass die Informationen zugänglicher klarer und einheitlicher sind. Außerdem wurden mehrere Anstrengungen unternommen um die Lesbarkeit des Textes zu verbessern sodass alle Studierenden postgradualen Mediziner Wissenschaftler und Fachkräfte im Gesundheitswesen mit geringem Aufwand Wissen erwerben können. Dieses Buch wurde in erster Linie zur Aktualisierung Neuorganisation und Neuausrichtung auf bakterielle virale und parasitäre Krankheiten verfasst. Abschnitt 1 behandelt die grundlegenden mikrobiologischen Konzepte und Abschnitt 2 die genauen Details der verschiedenen mikrobiologischen Krankheiten. Das Buch untersucht wie die Zitate die wesentlichen Tipps und Faktenblätter zu Krankheiten und ihrer Pathogenese Epidemiologie Diagnose Kontrolle und Behandlung besser zusammenfassen können und setzt dabei auf eine frühzeitige Diagnose eine schnelle Behandlung Kontrolle und zukünftige Ausrottung.
Delivery Options
Please enter pincode to check delivery time.
*COD & Shipping Charges may apply on certain items.
Review final details at checkout.
Details
ISBN 13
9786208750848
Publication Date
-17-03-2025
Pages
-132
Weight
-190 grams
Dimensions
-152x229x7.86 mm